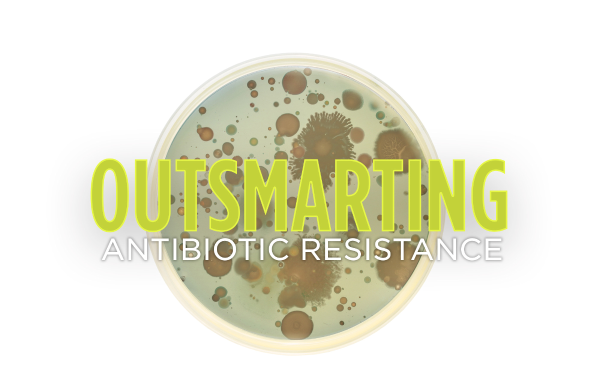

James M. Tiedje, Ph.D.
Courses Taught:
- CSS 360, Soil Biology
- CSS 455, Fate of Pollutants in the environment (1/3)
- MMG 801, Integrative Microbial Biology (lectures)
Websites of Interest:
- Tiedje Lab Website
- Click here to see a list of James M. Tiedje's publications on Google Scholar.
Former Students:
Past graduate students, post-docs and visiting scholars, over 100.
Publications:
- Tiedje, James and Timothy Donohue. 2008. Microbes in the Energy Grid. Science - Editorial, 320: 985
- Yoder-Himes, D, P.S. Chain, Y. Zhu, O. Wurtzel, E.M. Rubin, J.M. Tiedje, R Sorek. 2009. Mapping the Burkholderia cenocepacia niche response via high-throughput sequencing. PNAS 106:3976-81.
- Rodríguez-Minguela, Carlos. M, J. H. Apajalahti, B. Chai, J. R. Cole and J. M. Tiedje. 2009. Worldwide prevalence of class 2 integrases outside the clinical setting is associated with human impact. Appl Environ. Microbiol. 75:5100-10.
- Jesus, Ederson da C, T. L. Marsh, J. M. Tiedje and Fatima M. de S Moreira. 2009. Changes in land use alter the structure of bacterial communities in Western Amazon soils. ISME J. 3:1004-10
- Konstantinidis, K.I., M.H. Serres, M.F. Romine, J. L.M.Rodrigues, J. Auchtung, L.A. McCue, M.S. Lipton, A. Obraztsova, C.S. Giometti, K.H. Nealson, J.K. Fredrickson, and J.M. Tiedje. 2009. Comparative systems biology across an evolutionary gradient within the Shewanella genus. PNAS 106:15909-15914.
- Bergholz, P.W., C. Bakermans and J.M. Tiedje. 2009. Psychrobacter arcticus 273-4 uses resource efficiency and molecular motion adaptations for subzero temperature growth. J. Bacteriol. 191:2340-2352.
- Sul, W.J., J-H. Park, J.F. Quensen III, J.L.M. Rodrigues, L. Seliger, T.V. Tsoi, G.J. Zylstra and J.M. Tiedje. 2009. DNA-Stable isotope probing integrated with metagenomics for retrieval of biphenyl dioxygenase genes from polychlorinated biphenyl-contaminated river sediment. Appl. Environ. Microbiol. 75:5501-5506
- Walk, S.T., E.W. Alm, D.M. Gordon, J.L. Ram, G.A. Toranzos, J.M. Tiedje, and T.S. Whittam. 2009. Cryptic lineages of the Escherichia genus. Appl. Environ. Microbiol. 75-6534-6544.
- Iwai, S., B. Chai, W.J. Sul, J.R. Cole, S.A. Hashsham and J.M. Tiedje. 2009. Gene-targeted-metagenomics reveals extensive diversity of aromatic dioxygenase genes in the environment. ISME Journal 4:279-285.
- Jesus, Ederson da, E. Susilawat, S. L. Smith, Q. Wang, B. Chai, R. Farris, J. L. M. Rodrigues, K.D. Thelen and J. M. Tiedje. 2010. Bacterial communities in the rhizosphere of biofuel crops grown on marginal lands as evaluated by 16S rRNA gene pyrosequences. Bioenerg. Res. 3:20-27. DOI 10.1007/s12155-009-9073-7.
- Luo, C, S. Walk, D. M. Gordon, M. Feldgarden, J. Tiedje and K. T. Konstantinidis. 2011. Genome sequencing of environmental E. coli expands understanding of the ecology and speciation of the model bacterial species. PNAS 108:7200-7205.
- Iwai S, T. A. Johnson, B. Chai, S. A. Hashsham, and J. M. Tiedje. 2011. Comparison of the specificity and efficacy of primers for aromatic dioxygenase gene analysis of environmental samples. Minireview. Appl. Environ. Microbiol. 77: 3551-3557.
- Rodrigues, J. L. M., M. H. Serres, and J. M. Tiedje. 2011. Large scale comparative phenotypic and genomic analyses reveal ecological preferences of Shewanella species and identify metabolic pathways conserved at genus level. Appl. Environ. Microbiol. DOI 10.1128/AEM.01097-11.
- Looft T, T. A. Johnson, H.K. Allen, D.O. Bayles, D.P. Alt, R.D. Stedtfeld, W.J. Sul, T.M. Stedtfeld, B. Chai B, J. R. Cole, S.A. Hashsham, J.M.Tiedje and T.B. Stanton. 2012. In-feed antibiotic effects on the swine intestinal microbiome. PNAS 109 (5) 1691-1696.
- Pell, J., A. Hintze, R. Canino-Koning, A. Howe, J. M. Tiedje and C. T. Brown. 2012. Scaling metagenome sequence assembly with probabilistic de Bruijn graphs. PNAS 109:13272-13277.
- Penton, C. R., J. L. Deenik, B. N. Popp, G. L. Bruland, P. Engstrom, D. St. Louis, G. A. Brown and, J. Tiedje. 2012. Importance of sub-surface rhizosphere-mediated coupled nitrification-denitrification in a flooded agroecosystem in Hawaii. Soil Biol Biochem. 57:362-373.
- Rodrigues, J. L. M.; V. Pellizari, R. Mueller, K-H, Baek, E. C Jesus, F. Paula, B. Mirza, G. Hamaoui, S.M. Tsai, B. Feigl, J. M. Tiedje, Brendan J.M. Bohannan and Klaus Nüsslein. 2012. Conversion of the Amazon Rainforest to agriculture results in biotic homogenization of soil bacterial communities. PNAS 110:988-993
- Zhu, Yongguan, Timothy A. Johnson, Jian-Qiang Su, Min Qiao, Guang-Xia Guo, Robert D. Stedtfeld, Syed A. Hashsham, and James M. Tiedje, 2013. Diverse and abundant antibiotic resistance genes in Chinese swine farms, PNAS 110:3435-3440
Related Work
-
Four faculty ranked for their global publication power
Published on November 16, 2022
-
Tiedje elected Foreign Member of Chinese Academy of Sciences
Published on December 22, 2021
-
MSU recognized as global leader in environmental antimicrobial resistance research
Published on March 17, 2021
-
New report says six MSU AgBioResearch scientists among most highly cited
Published on December 3, 2019
-
MSU AgBioResearch scientist talks to National Geographic about antibiotic resistance
Published on June 6, 2016
-
Outsmarting antibiotic resistance
Published on March 9, 2016
-
Getting the Scoop on Soil
Published on July 27, 2015
-
Soil microbes could be the key to healthier, stronger plants
Published on June 18, 2015
-
The driving force: Technological innovations accelerate environmental antibiotic resistance research
Published on June 10, 2014

Print
Print Email
Email